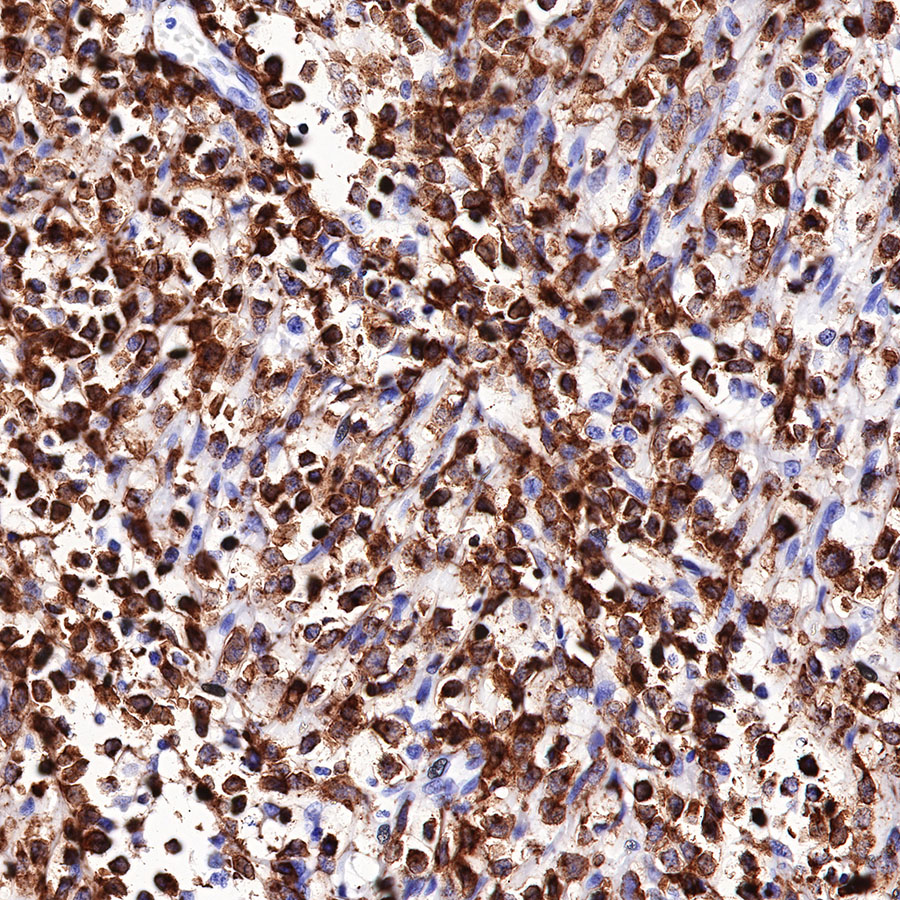

Product Details
Product Details
Product Specification
| Host | Rabbit |
| Antigen | CD7 |
| Synonyms | T-cell antigen CD7, GP40, T-cell leukemia antigen, T-cell surface antigen Leu-9, TP41 |
| Immunogen | N/A |
| Location | Membrane |
| Accession | P09564 |
| Clone Number | SDT-R165 |
| Antibody Type | Recombinant mAb |
| Application | WB, IHC-P, ICC, IP |
| Reactivity | Hu |
| Purification | Protein A |
| Concentration | 0.25 mg/ml |
| Physical Appearance | Liquid |
| Storage Buffer | PBS, 40% Glycerol, 0.05% BSA, 0.03% Proclin 300 |
| Stability & Storage | 12 months from date of receipt / reconstitution, -20 °C as supplied |
Dilution
| application | dilution | species |
| WB | 1:500 | null |
| IHC-P | 1:1000 | null |
| ICC | 1:125 | null |
| IP | 1:25 | null |
Background
CD7 is a single-domain Ig superfamily molecule expressed on human T and NK cells, as well as on cells in the early stages of T, B, and myeloid cell differentiation. CD7 is highly expressed on malignant immature T cells and is generally absent on malignant mature T cells [PMID: 10530432]. CD7 is Lymphoid marker, which expressed in 30% of AML cases and linked with poor prognosis in myeloid malignancies [PMID: 21148082].
Picture
Picture
Western Blot

IP

CD7 Rabbit mAb at 1/25 dilution (1 µg) immunoprecipitating CD7 in 0.4 mg Jurkat whole cell lysate.
Western blot was performed on the immunoprecipitate using CD7 Rabbit mAb at 1/1000 dilution.
Secondary antibody (HRP) for IP was used at 1/400 dilution.
Lane 1: Jurkat whole cell lysate 50 µg (Input)
Lane 2: CD7 Rabbit mAb IP in Jurkat whole cell lysate
Lane 3: Rabbit monoclonal IgG IP in Jurkat whole cell lysate
Predicted MW: 25.4 kDa
Observed MW: 37 kDa
Immunohistochemistry

Immunocytochemistry


